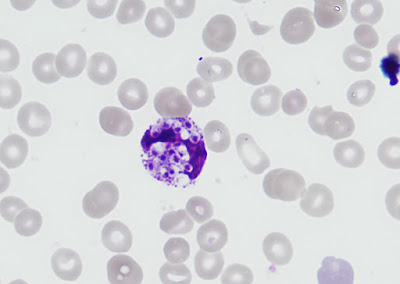

The following objects were seen on a thin blood smear that was made to evaluate a patient for malaria. No further history is available. Images courtesy of Emily Fernholz.
Identification?
Tuesday, May 1, 2018
Subscribe to:
Post Comments (Atom)

13 comments:
HIV status?
I've seen Histoplasma do this, but only in immunocompromised persons (and would that organism be too drastic a departure from your usual subject matter?)
Leish would be unusual and i don't see clear kinetoplasts . . . toxo would be equally (if not more) unusual.
I'm stumped, but clearly not malaria!
This should be Histoplasma capsulatum - likely severe / disseminated. The more senior consultants here at Mayo Rochester have seen more of this than the younger ones - particularly with compromised patients such as those with late stage AIDS early in the HIV epidemic.
Looks like amastigotes... Leishmaniasis?
I'd favor histoplasma; no kinetoplast.
From the last case, we do not see the dot-dash pattern of Leishmania sp.
We do not see the cross wall of P. marneffi tissue form and there is no travel history which would indicate this agent. The organisms are not intraerythrocytic, this helps us eliminate malaria and babesia sp.
The cells are inside either a monocyte or macrophage, this may indicate histoplasmosis instead.
Let's see what is the correct diagnosis.
Florida Fan
Histoplasma capsulatum
Carlo Alberto Varlani
I'm also thinking about Histoplasma.
Luis
I believe this is likely to be Histoplasma sp. These cytoplasmic inclusions appear capsular, but because there also appears to be a clear zone, or "halo" cryptococcus is also a possibility. I agree that it would be helpful to know the patient's immune status and history. Invasive disease of this level points to a severly immunocompromised patient. Fungal culture results should yield a definitive answer in this case.
Sweet Magnolia,
Cryptococcal cells usually present themselves as spherical or subglobose yeast with or without a bud or daughter cell. They also may have a more or less pronounced capsule. These cells are rather oval and as such, I would confidently rule out this possibility.
Best regards from Sydney,
Florida Fan
Plasmodium Malariae
Histoplasma capsulatum.....not a leishmania as we had such clear pics of last case ... Not malaria size too big for shizonts ..... immunocompromised pt I feel as some have mentioned
Giant platelet?
I agree with histoplasmosis...
Post a Comment